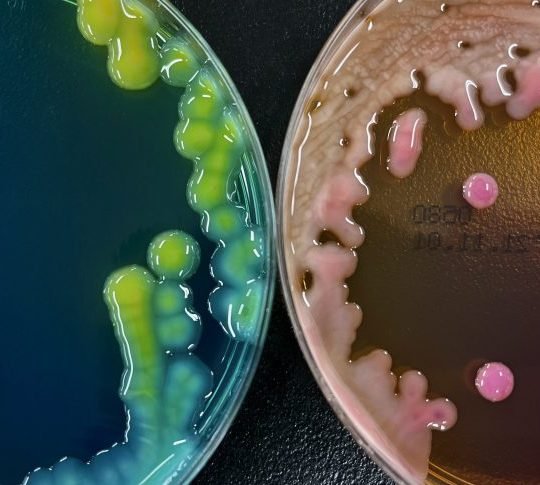

Arranca Programa de Vivienda en Puebla; serán 48,700 casas nuevas en sexenio
Por: Redacción Criterio Diario /Foto: X: @Segob_Puebla En Puebla, como parte del Programa Nacional de Vivienda, se construirán 48 mil 700 nuevas casas que se entregarán a través del Infonavit y la Conavi, además de 20 mil acciones serán para entrega de escrituras; el estado y municipios darán las facilidades para su ejecución. Lo anterior, durante el arranque de […]
Seguir Leyendo...